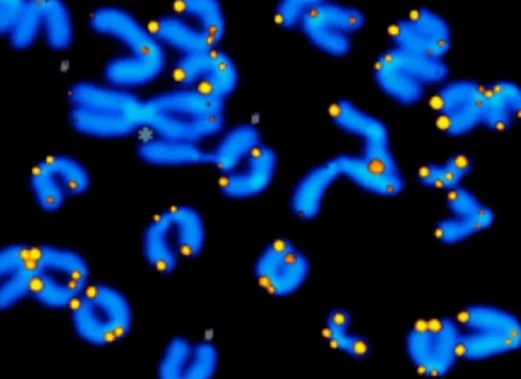

مقابله با پیری به یاری آنزیم تلومراز
به گزارش وبلاگ وکیل من، خبرگزاری خبرنگاران-زمانی که سلول های بالغ نظیر فیبروبلاست های پوست به سلول های بنیادی (موسوم به سلول های-iPS) تبدیل می شوند، عملا جوان شده اند و آنزیم تلومراز در آن ها فعال می گردد اینطور می گردد با پیری مقابله کرد.
به گزارش خبرگزاری وبلاگ وکیل من به نقل از روابط عمومی معاونت علمی و فناوری ریاست جمهوری، آنزیم تلومراز نقش مهمی در ممانعت از پیرشدن سلول های بنیادی دارد و آن ها را نامیرا می سازد، پس شاید بتوان آن را آنزیم جوانی نامید.
در واقع زمانی که سلول های بالغ نظیر فیبروبلاست های پوست به سلول های بنیادی (موسوم به سلول های-iPS) تبدیل می شوند، عملا جوان شده اند و آنزیم تلومراز در آن ها فعال می گردد؛ بنابراین مطالعات زیادی درباره ظرفیت تلومراز برای مقابله با پیری سلولی و بعلاوه مقابله با فرآیند پیری در ما انسان ها صورت گرفته و در حال اجرا است، اما فقط یک نگرانی وجود دارد و آن اینکه، این آنزیم در سلول های سرطانی هم به پیرنشدن و نامیراشدن آن ها یاری می نماید، بنابراین فعال سازی مجدد تلومراز می تواند بالقوه سرطانزا باشد و خاموش کردن آن هم می تواند سلول های پرتکثیر و سلول های بنیادی را از کار بیندازد.
این یکی از چالش های محققان زیست - پزشکی است.
منبع: خبرگزاری آریا